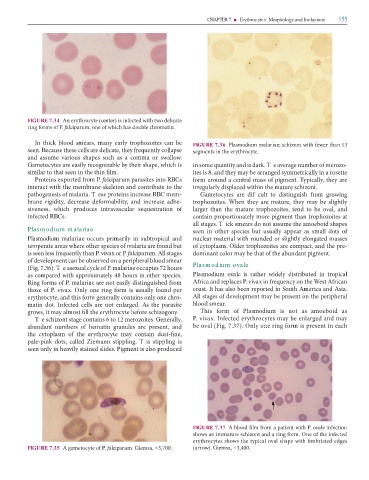

Page 171 - Clinical Hematology_ Theory _ Procedures ( PDFDrive )
P. 171
CHAPTER 7 ■ Erythrocytes: Morphology and Inclusions 155
FIGURE 7.34 A (center)
m P. alciparum, m .
I k m , m z FIGURE 7.36 Plasmodium malariae: z
. B , q m .
m mm .
G m z , m q k. T m m z -
m m. , m mm
P x m P. alciparum RBC m m m . ,
m m k m z .
m . T RBC m m- G m f m
, m , - z . W m , m
, q m z , ,
RBC . m m z
. T k m m m
Plasm odium m alariae m
Plasmodium malariae m m m
m m m. O z m , -
q P. vivax P. alciparum. A m m m .
m m
(F . . ). T x P. malariae Plasm odium ovale
m x m . Plasmodium ovale
R m P. malariae m A P. vivax q W A
P. vivax. O m . I S Am A .
, m - A m m
m . I . A m .
, m m z . m Plasmodium m
T z m z . G , P. vivax. I m m
m m , (F . . ). O m
m m - ,
- k , Z m . T
. P m
FIGURE 7.37 A m m P. ovale
mm z m. O
m
FIGURE 7.35 A m P. alciparum. G m , × , . (arrow). G m , × , .